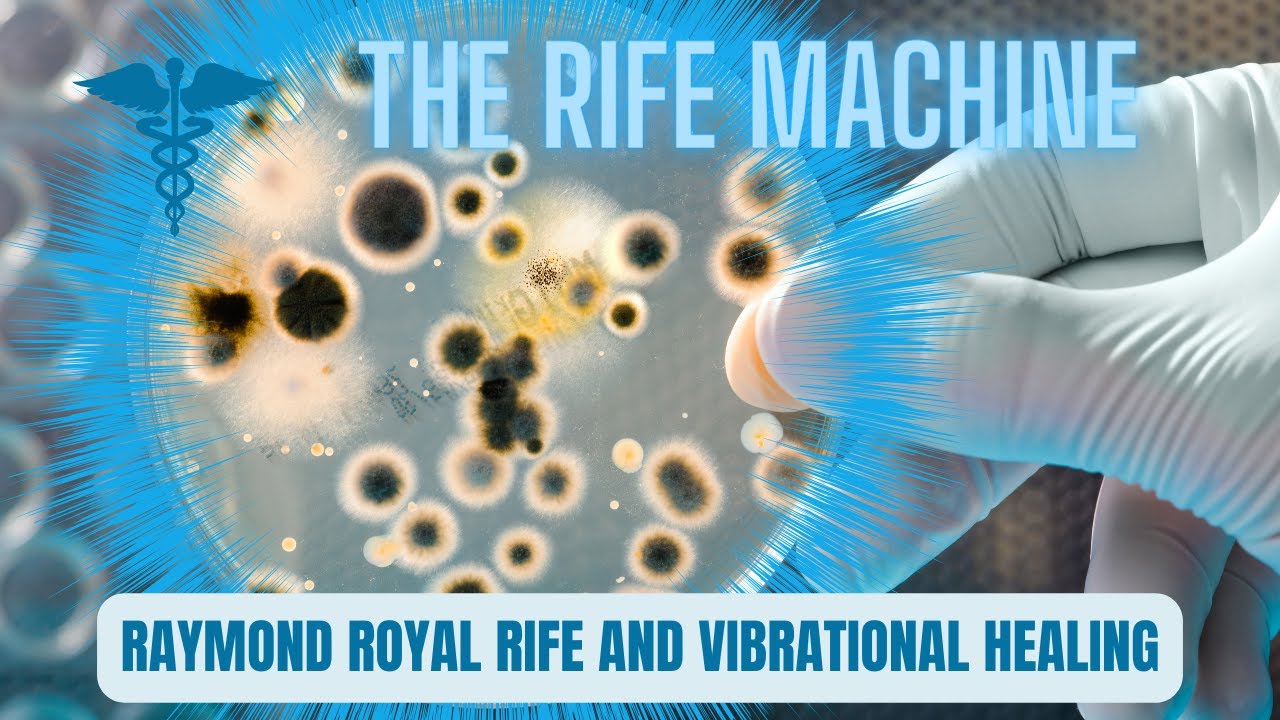
Unlocking Wellness: Exploring the Revolutionary Rife Machine

Последние добавленные видео:
rife-therapy
-
 4 года назад
478 4 года назад 2:16
4 года назад
478 4 года назад 2:16RifeTherapy - The Corpus Naturalis Clinic | Rife Therapy
-
 10 лет назад
783 10 лет назад 1:50
10 лет назад
783 10 лет назад 1:50Rife Therapy
-
 2 года назад
9052 2 года назад 53:21
2 года назад
9052 2 года назад 53:21Comprehensive Rife Frequency Therapy: Targeting Cancer, Parasites, and Fungus
-
 5 лет назад
9276 5 лет назад 2:33
5 лет назад
9276 5 лет назад 2:33Rife Therapy - Use Healing Frequencies for Inner Resonance
-
 7 месяцев назад
16861 7 месяцев назад 49:44
7 месяцев назад
16861 7 месяцев назад 49:44Penny Rife: Healing Frequencies: The Power of Rife Therapy
-
 2 года назад
838 2 года назад 44:49
2 года назад
838 2 года назад 44:49Conversations with Experts - Rife Therapy
-
 2 года назад
23 2 года назад 9:07
2 года назад
23 2 года назад 9:07Remote Rife Therapy What to Expect
-
 1 год назад
8522 1 год назад 10:06
1 год назад
8522 1 год назад 10:06Dr. Rife's Healing Frequencies for BACTERIAL & VIRAL CLEANSE | 10-Minute Therapy Sound
-
 2 года назад
1962 2 года назад 43:06
2 года назад
1962 2 года назад 43:06RIFE THERAPY & FREQUENCY HEALING WITH SPOOKY2
-
2 года назад
11162 2 года назад 8:14
2 года назад
11162 2 года назад 8:14Unlocking Wellness: Exploring the Revolutionary Rife Machine
-
 1 год назад
155139 1 год назад 15:00
1 год назад
155139 1 год назад 15:00Support Teeth Gum and Dental Wellness I RIFE-Inspired Sound Therapy for Oral Vitality
-
 7 лет назад
2747 7 лет назад 1:01
7 лет назад
2747 7 лет назад 1:01Rife Therapy | Health Optimizing Clinic Dublin
-
 4 года назад
1746 4 года назад 1:44
4 года назад
1746 4 года назад 1:44ITC - Dr. Pablo Orozco Rife Therapy
-
 6 месяцев назад
7018 6 месяцев назад 16:43
6 месяцев назад
7018 6 месяцев назад 16:43Терапия болезни Паркинсона и Райфа: частотные машины против реальных исследований
-
 7 лет назад
450 7 лет назад 9:16
7 лет назад
450 7 лет назад 9:16Rife Therapy For Cancer